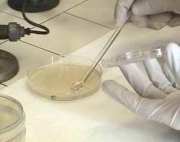

MADDALONI. Si terrà sabato 20 giugno, a partire dalle 8, presso
MADDALONI. Si terrà sabato 20 giugno, a partire dalle 8, presso
Il corso, patrocinato dall’Amcli (Associazione dei Microbiologi Clinici Italiani), è rivolto ai professionisti del laboratorio, laureati e tecnici con l’obiettivo di fornire un quadro dell’evoluzione delle resistenze batteriche e dei nuovi meccanismi di resistenza, indicazioni sulle potenzialità e i limiti delle metodologie impiegate per eseguire l’antibiogramma e dei sistemi esperti associati ai sistemi automatici, conoscenza dell’importanza di un corretto e costante controllo di qualità interno e dell’adesione ai programmi Veq, indicazioni sull’utilità dei dati ottenuti con l’antibiogramma per il monitoraggio delle resistenze batteriche.
Nell’esercitazione pratica sui profili di resistenza a fenotipi impossibili i docenti potranno interagire direttamente con i discenti, con quesiti e risposte fornite in tempo reale. La discussione interattiva sui dati di sorveglianza delle antibiotico-resistenze rilevate nell’ospedale Cardarelli di Napoli sarà una modalità privilegiata per evidenziare le reali criticità nell’esecuzione e interpretazione degli antibiogrammi nella pratica quotidiana. Il coordinamento scientifico del corso è affidato alle dottoresse Marisa Del Pezzo, Universitaria Federico II di Napoli, Lidia Barletta, della Casa di Cura San Michele e Laura Pagni, Dipartimento Smec Sezione Microbiologia Università di Pavia; presiederà il professor Fabio Rossano, Direttore dell’Unità Complessa di Microbiologia del Dipartimento Assistenziale di Patologia Clinica dell’Azienda Ospedaliera Universitaria Federico II. Modereranno gli interventi il prof. Francesco Saverio Faella, Direttore del Dip. delle Urgenze Infettivologiche e di Terapia Intensiva. Azienda ospedaliera Cotugno-Napoli, il professor Riccardo Smeraglia, Direttore della Microbiologia e Virologia dell’Ospedale “V.Monaldi” e la professoressa Maria Triassi, Direttore del Dipartimento Assistenziale di Igiene Ospedaliera, Medicina del Lavoro e di Comunità dell’Azienda Universitaria Policlinico Federico II di Napoli.
Le relazioni in programma saranno tenute da professionisti provenienti dall’intero territorio nazionale. Interverranno, infatti, la professoressa Laura Pagni, il dottor Pasquale Cristiano, Casa di Cura San Michele, il dr. Gerardino Amato, Azienda Ospedaliera A. Cardarelli di Napoli, il professor Giovanni Pietro Gesu, A.O. Niguarda Cà Granda – Milano, la professoressa Roberta Migliavacca, Dip. Smec Sez. Microbiologia Università degli Studi Pavia, il professor Francesco Luzzaro, Ospedale di Circolo e Fondazione Macchi – Varese e il dr Mario Sarti, Ospedale S. Agostino Estense Azienda Usl di Modena. Il corso rientra nel Programma nazionale di educazione continua in medicina del Ministero della Salute.

